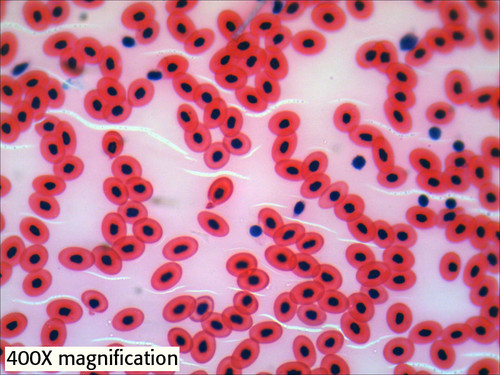

Home ⇨ Frog blood cells labeled
Frog Blood Cells Labeled
Download Frog blood cells labeled For Android - Make the most of your display with beautiful wallpapers and advanced features. Choose one of your own photos, an image from the Google Earth collection. Today i will share Frog blood cells labeled wallpaper. Download wallpapers for desktop free. High Quality HD pictures wallpapers.

Get Frog blood cells labeled Free













































.jpg)